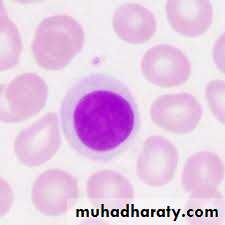
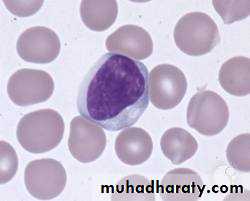

CLINICAL IMMUNOLOGY
AL-ABBASI A.M.,MD, PhD, FRCP, DCN, DTM&H
PROFESSOR OF INFECTIOUS DISEASES AND CLINICAL IMMUNOLOGY
Clinical ImmunologyDefense MechanismsNon Immunological
Skin
Mucous membrane
Saliva, tears
Respiratory cilia
Cough & expectoration
Gastric acidity
Peristalsis
Flash of urine
Vaginal acidity
Immunological
Complement system
Phagocytosis
Opsonization
Antibody Compl. Fixation
Neutralization
Lyses
Agglutination
Cell Mediated Immunity
OPSONIZATION
ImmunologyA study of our protection from foreign macromolecules or invading organisms and our responses to them.
Invaders include viruses, bacteria, protozoa or even larger parasites.
In addition, an immune responses against:
Our own proteins (and other molecules) in AutoimmunityAgainst our own aberrant cells in:
Tumor immunity.MAJOR PRIMARY ORGANS OF IMMUNE SYSTEM
THYMUSBONE MAROW
MONOCYTE
MACROPHAGEMYELOID
LYMPHOID
(B &T cells)
ERYTHROID
(RBCs)
PMNs
EOSINOPHILsBASOPHILS
PLASMA: Liquid component of blood containing clotting factors
SERUM: Liquid component of blood lacking clotting factors
GRANULOCYTE
MONOCYTE
T cells
B cells
NK cells
MYELOID
IMMUNE SYSTEM
LYMPHOID
PMNs
Basophile
Eosinophils
Macrophage
Kupffer cells
Dendritic cells
Helper
Suppressor
Cytotoxic
Plasma cells
If, first line penetrated,
the body contains cells that respond rapidly to the presence of the invader.Soluble molecules deprive the invading organism of essential nutrients (Fe++) and from certain molecules on the surfaces of epithelia.
Chemical factors
Fatty acids in sweat inhibit growth of bacteria.Lysozyme and phospholipase in tears, saliva and nasal secretions can breakdown cell wall of bacteria and destabilize bacterial membranes.
low pH of sweat and gastric secretions prevents growth of bacteria.
Defensins (low molecular weight proteins) in the lung and GIT have antimicrobial activity.Surfactants in the lung act as opsonins for phagocytosis.
Biological factorsNormal flora of skin and GIT prevent colonization of pathogenic bacteria by secreting toxic substances or by competing with pathogenic bacteria for nutrients or attachment to cell surfaces.
PERIPHERAL BLOOD FILM
Second lineSpecific or adaptive immune system:
Abs and CMI
Specific cells recognize foreign pathogens and destroy them.
In the case of viruses or tumors, this response is also vital to the recognition and destruction of virally-infected or tumorigenic cells.
The response to a second round of infection is more rapid than to the primary infection activation of memory B and T cells.
Coordinated response will be mounted.
Lymphokines produced by cells of the lymphoid system,cytokines and chemokines stimulate cells of the immune system.
Comparison between Innate & Adaptive immunity
Innate defenses constitutively present and readily mobilized upon infectionNot antigen specific and reacts equally well to a variety of organisms
Does not demonstrate immunological memory.The adaptive immune system requires some time to react to an invading organism.
Antigen specific and reacts only with the organism that induced the response.
Demonstrates immunological memory.Reacts more rapidly on subsequent exposure to the same organism.
HUMORAL BARRIERS TO INFECTION• 1/Complement system
It is the major humoral nonspecific defense mechanism.
Once activated complement can lead to increased vascular permeability, recruitment of phagocytes' cells, lyses and opsonization of bacteria.
CLASSICAL PATHWAY ALTERNATIVE PATHWAY
Antibody dependant Not antibody dependant
C1q, r,s + Ca++ P, B, Bp +Mg++
C4, C2
C3 C3a + C3b
C5a, C5b C5
C6, 7, 8, 8 MAC
2. Coagulation system
Depending on the severity of the tissue injury, it may or may not be activated.Some products of the coagulation system can contribute to the nonspecific defenses because of their ability to increase vascular permeability and act as chemo tactic agents for phagocytic cells.
Some of products of the coagulation system are directly antimicrobial e.g. β- lysine, a protein produced by platelets during coagulation can lyse many Gram + bacteria by acting as a cationic detergent.
3. Lactoferrin and transferrin
By binding iron, an essential nutrient for bacteria, these proteins limit bacterial growth.4. Interferon's
Interferon's are proteins that can limit virus replication in cells.5. Lysozyme
Breaks down the cell wall of bacteria.
6. Interleukin-1
Il-1 induces fever and the production of acute phase proteins, some of which are antimicrobial because they can opsonize bacteria.IgA dimer
IgM pentamer
IgG monomer
Cellular barriers to infection
• 1. Neutrophils – (PMNs) recruited to the site of infection where they phagocytose invading organisms and kill them intracellular.• PMNs contribute to collateral tissue damage that occurs during inflammation.
2. Macrophages
Tissue macrophages and newly recruitedmonocytes, which differentiate into
macrophages, also function in
phagocytosis and intracellular killing of
microorganisms.
In addition, macrophages are capable of extracellular killing of infected or altered self target cells.
Contribute to tissue repair and act as antigen presenting cells, which are required for the induction of specific immune responses.
3. Natural killer (NK)
and lymphokine activated killer (LAK) cellsNK and LAK cells can nonspecifically kill virus infected and tumor cells.
These cells are not part of the inflammatory response but they are important in nonspecific immunity to viral infections and tumor surveillance.4. Eosinophils
have proteins in granules effectivein killing certain parasites.
Non-specific Killer Cells
Several different cells including NK and LAK cells, K cells, activated macrophages and eosinophils are capable of killing foreign and altered self target cells in a non-specific manner.
These cells play an important role in the innate immune system.
K cellsNK cells a type of cytotoxic lymphocyte critical to the innate immune system.
Rather a K cell is any cell that mediates antibody-dependent cellular cytotoxicity (ADCC).
In ADCC antibody acts as a link to bring the K cell and the target cell together to allow killing to occur.
K cells have on their surface an Fc receptor for antibody and thus they can recognize, bind and kill target cells coated with antibody.
Killer cells which have Fc receptors include NK, LAK, and macrophages which have an Fc receptor for IgG antibodies and eosinophils which have an Fc receptor for IgE antibodies.